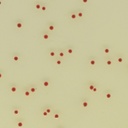
CHROMagar™ Campylobacter

CHROMagar™ Campylobacter
Catalog No :
CAS Number :
Brand :
In Stock
For detection, differentiation and enumeration of thermotolerant Campylobacter
Specifications:
| Application | Microbiology | ||
| Storage Temperature | Room Temperature | ||
| Product Type | Culture Medium | Forms | Powder |
| Product Brand | CHROMagar™ | ||
| Product Grade | Microbiology grade | ||
For Detection, Differentiation, and Enumeration of Thermotolerant Campylobacter spp.
CHROMagar™ Campylobacter is a highly selective chromogenic culture medium specifically designed for the isolation and enumeration of thermotolerant Campylobacter species, including C. jejuni, C. coli, and C. lari, from clinical, food, animal feed, and environmental samples. Colonies of thermotolerant Campylobacter appear intense red on a translucent agar background after 36–48 hours of incubation at 42 °C under microaerophilic conditions.
Validated in accordance with ISO 10272-1, this medium offers superior sensitivity, clean background selectivity, and user-friendly interpretation compared to conventional charcoal-based media.
🔹 Key Features & Benefits
- ✅ Distinct Red Colonies: Campylobacter jejuni, coli, and lari form easily identifiable red colonies against a translucent background—superior readability versus charcoal media.
- ✅ ISO 10272-1 Compliant: Approved for use in official control methods for food and feed safety testing.
- ✅ Highly Selective: Reinforced selectivity inhibits background flora, even in heavily contaminated specimens.
- ✅ High Recovery Rate (~100%): Proven high-performance medium for detection and enumeration of thermotolerant Campylobacter.
- ✅ Versatile Application: Suitable for clinical diagnostics (stool, rectal swabs) and microbiological control in food and environmental labs.
🔹 Colony Appearance
| Organism | Colony Appearance |
|---|---|
| Campylobacter jejuni/coli/lari | Red |
| Background flora | Inhibited or non-red |
🔹 Intended Use
CHROMagar™ Campylobacter is intended for:
- Qualitative detection, differentiation, and enumeration of thermotolerant Campylobacter spp.
- Stool and rectal swab screening in clinical microbiology for presumptive diagnosis
- Food safety testing, especially poultry and meat products
- Environmental and feed sample analysis under ISO 10272-1 framework
⚠️ This medium is not intended to diagnose infection or guide treatment. Confirmatory testing (e.g., MALDI-TOF, PCR) should follow presumptive identification.
🔹 Clinical & Public Health Context
According to the World Health Organization (WHO), Campylobacter spp. are the leading bacterial cause of foodborne diarrheal illness worldwide, responsible for more gastroenteritis cases than Salmonella. Infections are particularly severe in children under 2 years in developing countries and in immunocompromised patients.
📌 "The high incidence, prolonged symptoms, and potential complications of Campylobacter infection make early detection critical from both public health and economic perspectives."
(WHO Fact Sheet No. 255)
🔹 Test Procedure
- Sample Types: Stool, rectal swabs, poultry meat, animal feed, surface/environmental swabs
- Inoculation: Surface streaking or direct plating (dilution for enumeration)
-
Incubation:
- Temperature: 42 °C
- Time: 36–48 hours
- Atmosphere: Microaerophilic
-
Interpretation:
- Red colonies = presumptive Campylobacter spp.
- Other flora = inhibited or non-specific
🔹 Ordering Information
| Product Description | Reference Code | Components Included |
|---|---|---|
| CHROMagar™ Campylobacter 5000 mL Pack | CP572 | Base CP572(B) + Supplement CP572(S) |
| CHROMagar™ Campylobacter 25 L Pack | CP573-25 | Base CP573-25(B) + Supplement CP573-25(S) |
🔹 Storage & Shelf Life
- Storage: 2–8 °C, sealed and protected from light
- Shelf Life: Up to 24 months when stored properly
- Prepared Plates: Use within manufacturer-recommended timeframe
CHROMagar™ Campylobacter is a powerful tool for selective and easy identification of thermotolerant Campylobacter spp., offering superior recovery, ISO compliance, and visual clarity. With its rapid results, high specificity, and clean background, it is the ideal medium for food safety, clinical screening, and environmental monitoring of Campylobacter, the world's most common cause of bacterial gastroenteritis.
- Pack Size: 5000 mL Pack (Base medium + Supplement) 25 L Pack (Base medium + Supplement)




 0
0